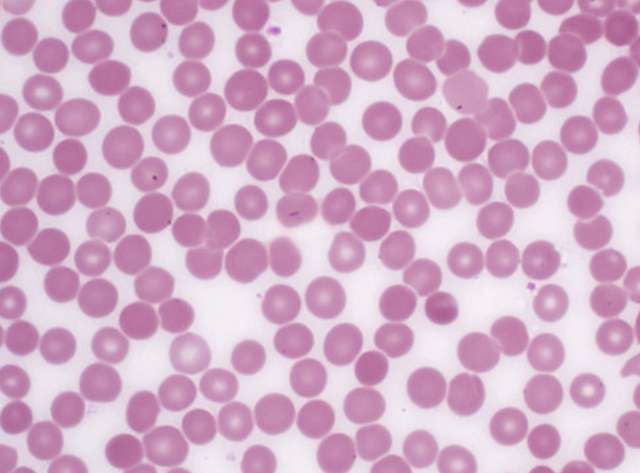
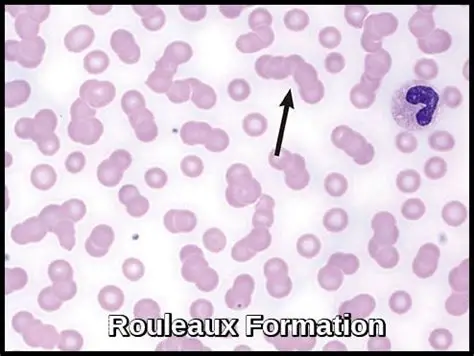

Mobiilisäteily saa verisolut paakkuuntumaan – voi aiheuttaa päänsärkyä ja aivohalvauksen
Suomenkielinen käännös: lääkäri Rauli Mäkelä. Lisähuomiot: S.M. Lähde: Strålskyddsstiftelsen, Ruotsi www.stralskyddsstiftelsen.se
Yhdysvaltalaiset tutkijat ovat ensimmäistä kertaa havainneet ultraäänen avulla reaaliajassa, että matkapuhelinsäteily aiheuttaa verisolujen kasautumista yhteen. Tällä puolestaan voi olla monenlaisia sivuvaikutuksia ja vakavissa tapauksissa aiheuttaa aivohalvauksen tai sydänkohtauksen. Jo vuonna 2004 ruotsalainen fysiikan professori Bo Sernelius kuvasi teoreettisen fysiikan avulla, miten matkapuhelinsäteily aiheuttaa verisolujen kasaantumista.
Tähän asti punasolujen kokkaroituminen (punasoluaggregaatio, engl. rouleaux formation) on yhdistetty infektioihin, tulehduksiin, sidekudossairauksiin ja joihinkin syöpiin. Kun yhdysvaltalaistutkijat havaitsivat matkapuhelinsäteilylle altistumisen vaikutuksen ultraäänen avulla, langattomien tekniikoiden säteily voidaan lisätä tekijöihin, jotka voivat aiheuttaa tämän vaikutuksen veressä.
Punasolut kasaantuvat litteä puoli päällekkäin niin, että muodostuu niin sanottuja ”raharullia” (rouleaux), voi aiheuttaa monenlaisia ongelmia:
- Kun verisolut kasaantuvat yhteen, happi ei kulje yhtä tehokkaasti elimistössä, mikä voi vaikuttaa aineenvaihduntaan, energian saantiin ja jaksamiseen.
- Lisäksi veren virtaus voi hidastua, mikä aiheuttaa tukoksia pienemmissä verisuonissa. Pahimmassa tapauksessa tämä voi aiheuttaa aivohalvauksen tai sydänongelmia.
- Seurauksena voi olla myös päänsärkyä ja migreeniä, puutumista, väsymystä ja keskittymisvaikeuksia.

Aiemmin tätä ilmiötä on raportoitu tutkimuksissa, joissa verisoluja tutkittiin mikroskoopilla sen jälkeen, kun ne olivat altistuneet matkapuhelinsäteilylle laboratorioissa. Tutkijat ovat nyt kuitenkin ensimmäistä kertaa havainneet ultraäänen avulla reaaliajassa, että tämä häiriö ilmenee, kun terve ihminen altistuu matkapuhelinsäteilylle.
Radiologi ja yhdysvaltalaisen Environmental Health Trust -järjestön tieteellisen tutkimuksen ja kliinisten asioiden varajohtaja Robert Brown ja hänen kollegansa, ultraääniasiantuntija Barbara Biebrich tutkivat, voisivatko he ultraäänen avulla tarkkailla veressä tapahtuvia muutoksia sen jälkeen, kun henkilö on altistunut matkapuhelinsäteilylle, verrattuna siihen, miltä veri näytti ennen altistumista. Tulokset on julkaistu tieteellisessä julkaisussa Frontiers in Cardiovascular Medicine.
Ennen altistusta veri näytti normaalilta. Tämän jälkeen päälle kytketty matkapuhelin asetettiin henkilön syliin viideksi minuutiksi. Altistuksen jälkeen ultraäänitutkimus osoitti, että veri ei enää virrannut yhtä tasaisesti kuin aiemmin ja sisälsi paakkuuntuneita soluja. Koe toistettiin sen jälkeen kahdesti seuraavien kuukausien aikana, ja tulokset olivat samat.
Klorofyliini lehtivihreästä voi ehkäistä verihiutaleiden kokkaroitumista
Aikaisemmissa tutkimuksissa on havaittu, että ruoasta saatu klorofyliini (eng. chlorophyllin) saattaa ehkäistä tai vähentää verihiutaleiden kokkaroitumista ja toisiinsa tarttumista. Hyviä klorofyliinin lähteitä ovat kirjallisuuden mukaan klorellajauhe, vehnänoras- tai korianterilehtimehu ja alfalfan idut. Näiden lääkinnällistä tehoa ei kuitenkaan ole tutkittu laajalti, eivätkä ne yksinään suojaa kaikilta langattomien tekniikoiden säteilyhaitoilta. Säteilyn välttäminen tulisi siis olla ensisijainen suojautumiskeino.
Lähde ja lisää aiheesta ruotsiksi:
Suomen Säteilyturvan jäseneksi
Aktivoidu sinäkin – tule mukaan huolehtimaan meidän kaikkien tulevaisuudesta
Liittymällä yhdistyksemme jäseneksi voit omalta osaltasi vaikuttaa turvallisemman tulevaisuuden luomiseen.
Voit myös liittyä pelkästään sähköpostilistalle ja auttaa meitä yhdistyksellemme tärkeitä asioita.
Me Suomen Säteilyturva ry:ssä kannatamme langallisia verkkoja ilman langattomia signaaleja. Olemme omistaneet erillisen sivun kouluille, sivuillamme kohta Koulut. Sivuillamme kohdista Terveys ja Tietomateriaali voit lukea langattomien signaalien vaikutuksesta terveyteen. Esim. teknisiä ratkaisuja löydät kohdasta Riskienhallinta. Videot-kohdasta löytyy informatiivisia videoita. Mitä viranomaiset ja valmistajat sanovat? Ota selvää esitteestämme.